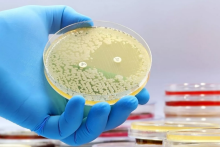

دانشمندان به کمک هوش مصنوعی توانستند پس از ۶۰ سال یک آنتیبیوتیک جدید کشف کنند
به گزارش سیتنا به نقل از یورونیوز، این باکتری که به شدت در مقابل داروها مقاوم است، سالانه هزاران نفر را در سراسر جهان میکشد و به همین دلیل کشف این آنتیبیوتیک، یک نقطه عطف در مبارزه با مقاومت باکتریها محسوب میشود.
جیمز کالینز، استاد مهندسی پزشکی در موسسه فناوری ماساچوست (MIT) و یکی از اعضای تیم تحقیق میگوید: «ایده کار این بود که توانایی مدلهای [هوش مصنوعی] برای پیشبینی اینکه برخی مولکولها آنتیبیوتیکهای خوبی هستند، ارزیابی شود. استفاده از دانش هوش مصنوعی باعث میشود که هم در زمان و هم در منابع صرفهجویی شود و تجزیه و تحلیل باکتریها و ساختار شیمیایی آنها را نیز به روشی که تا کنون ممکن نبوده، عملی خواهد کرد.»
گزارش یافتههای این تیم ۲۱ نفره در نشریه Nature منتشر شده است و در جریان این تحقیق، پژوهشگران از یک «مدل یادگیری عمیق» برای پیشبینی فعالیتها همچنین ترکیب این آنتیبیوتیک جدید استفاده کردند.
یادگیری عمیق (deep learning) به هوش مصنوعی اجازه میدهد تا ایدههای جدید را از مجموعه عظیمی از دادههای برنامهنویسی نشده بیاموزد و کشف کند. این شیوه به طور فزایندهای در تحقیقات پزشکی با هدف شناسایی داروهای بالقوه، پیشبینی خواص آنها و بهینه سازی فرآیند توسعه آنها استفاده میشود.
عفونتهای ناشی از باکتری «استافیلوکوکوس اورئوس» که در مقابل دارونیز مقاوم است، میتوانند از عفونتهای پوستی خفیف تا شرایط جدیتر و تهدید کننده زندگی مانند ذات الریه و عفونتهای خونی را در بر بگیرند.
گزارش مرکز پیشگیری و کنترل بیماریهای اروپا (ECDC) حاکی از آن است که هر ساله حدود ۱۵۰ هزار عفونت در همین ارتباط در سراسر اتحادیه اروپا روی میدهد و سالانه حدود ۳۵ هزار نفر نیز در این اتحادیه بر اثر این عفونتها جان خود را از دست میدهند.
تیم تحقیقاتی MIT به کمک «مدل یادگیری عمیق» حدود ۳۹ هزار ترکیب را برای شناخت فعالیتهای آنتیبیوتیکی آنها در قبال باکتری «استافیلوکوکوس اورئوس» مورد ارزیابی قرار دادند و دادهها و جزئیات به دست آمده در رابطه با ساختار شیمیایی ترکیبات را وارد این مدل کردند.
فلیکس وونگ، دیگر پژوهشگر این تحقیق میگوید: «کاری که ما در این مطالعه میخواستیم انجام دهیم، به نوعی باز کردن جعبه سیاه بود. این مدلها شامل محاسبات بسیار زیادی هستند که در واقع اتصالات عصبی را تقلید میکنند و هیچ کس واقعا نمیداند که در داخل این جعبه چه میگذرد.»
پژوهشگران میگویند به کمک این مدلها توانستند حدود ۱۲ میلیون ترکیب موجود را غربال و ترکیباتی را از پنج دسته مختلف شناسایی کنند که در برابر باکتری «استافیلوکوکوس اورئوس» نوعی فعالیت از خود نشان میدهند.
پس از آن، محققان حدود ۲۸۰ مورد از این ترکیبات را در برابر باکتری «استافیلوکوکوس اورئوس» آزمایش کردند و درنهایت توانستند دو ترکیب امیدبخش آنتیبیوتیکی شناسایی کنند.
آزمایشهای نهایی برای اثربخشی این آنتیبیوتیکها روی دو مدل موش انجام شد که یک گروه از آنها به عفونت پوستی «استافیلوکوکوس اورئوس» و دیگری به عفونت سیستمیک «استافیلوکوکوس اورئوس» دچار بودند و نتایج نشان داد که استفاده از این آنتیبیوتیک جدید باعث شده که میزان عفونتها در میان موشهای میزبان تا ۱۰ برابر کاهش یابد.
انتهای پیام
